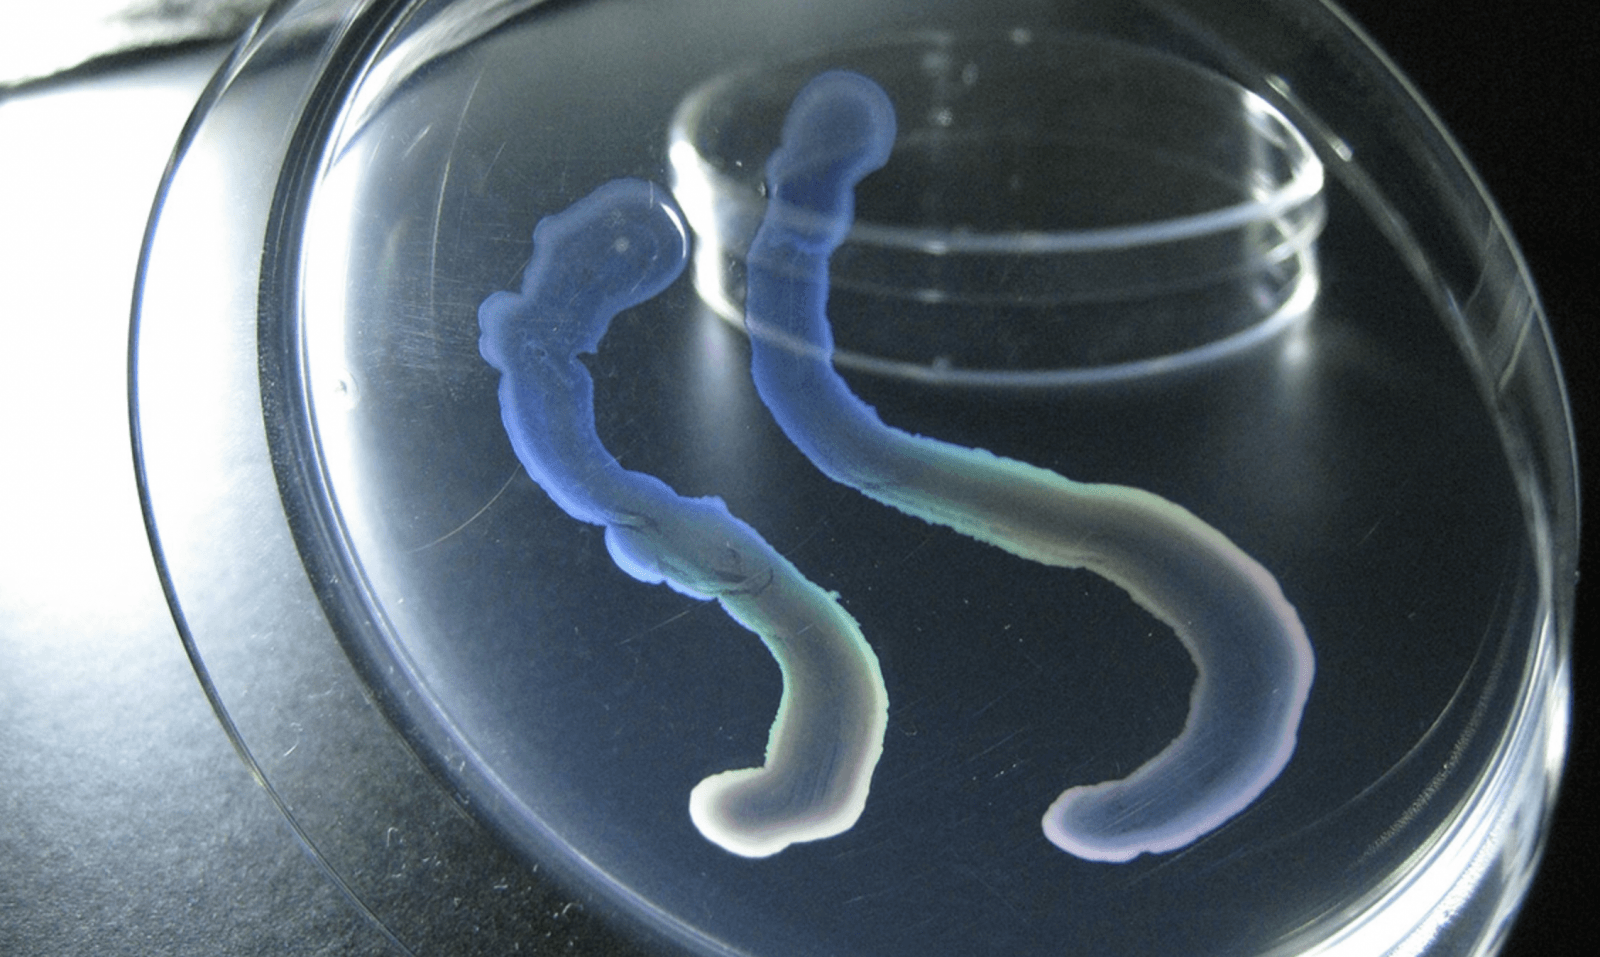
Szczep HS-3 w warunkach laboratoryjnych /Fot. Kouhei Mizuno

Nietypowy mikroorganizm znaleziony przez japońskich ekologów poszukujący biodegradowalnych tworzyw sztucznych zaczyna swój żywot jako pojedyncza komórka. Taki jednak nie pozostaje. W toku rozwoju zaczyna rozwijać zorganizowane “ciało” zbudowane z setek komórek. W odpowiednim momencie uwalnia nowe pokolenie pojedynczych komórek, aby zainicjować kolejny cykl życia. To niesamowite zachowanie, podobne do tego, które wykorzystują organizmy wielokomórkowe, jak rośliny czy ludzie. Szczegóły opisano w czasopiśmie Science.
Czytaj też:Na rozwiązanie zagadki czekano 50 lat. Wiadomo już, jak bakterie się poruszają
Niezwykły przypadek HS-3
Biolodzy wskazują na kilka ważnych momentów na osi czasu naszej planety, a jednym z kluczowych było niewątpliwie pojawienie się organizmów wielokomórkowych. Niektóre mikroorganizmy jednokomórkowe wykazują pewne proste aspekty zachowania grupowego, np. sinice tworzą złożone łańcuchy komórek czy bakterie z rodzaju Myxococcus formują się w mobilne “ciała”, które umożliwiają im przemieszczanie się w poszukiwaniu lepszych warunków.
Prof. Kouhei Mizuno z National Institute of Technology w Tokio 17 lat temu zebrał bakterię oznaczoną jako “HS-3” z jaskini na Kiusiu. Dopiero w warunkach laboratoryjnych okazało się, że nie jest to zwykły mikroorganizm. Japońscy uczeni odkryli, że gdy pojedyncze komórki HS-3 przylgną do powierzchni, zaczynają dzielić się na długie włókna, zaginające się i tworzące dwuwymiarowe warstwy podobne do tych występujących w ekranach urządzeń elektronicznych. Po ok. 5 dniach arkusz się zagęszcza, ponieważ nagromadziły się na nim nieprzezroczyste komórki w kształcie prętów. Kiedy zanurzono go w wodzie, komórki te wystrzeliwały z “ciała” bakterii, gotowe do założenia nowej kolonii. Naukowcy nie znają żadnego innego mikroorganizmu, który byłby do tego zdolny.
Warto zaznaczyć, że w przeciwieństwie do innych form bakterii wielokomórkowych, HS-3 nie miał różnych rodzajów komórek – wszystkie miały odrębną strukturę i powstawały w różnych momentach cyklu życiowego. Naukowcy sugerują, że powstawały one wręcz jako odpowiedź na specyficzne warunki środowiskowe (w tym przypadku zanurzenie w wodzie).
Czytaj też:Bakterie zombie – jak wybierają najlepszy moment, by wrócić do świata żywych?
Prof. Kouhei Mizuno mówi:
Jest w tym wszystkim pewna logika. HS-3 został zebrany ze ściany nad podziemnym strumieniem. Na tej ścianie może formować swoje ciało i gromadzić swoje pręcikowe komórki. Następnie, gdy deszcz powoduje, że strumień podnosi się, komórki te są uwalniane i rozpraszają się w środowisku.
Termin “wielokomórkowość” nie jest precyzyjnie zdefiniowany w biologii, więc nie można jednoznacznie stwierdzić, czy HS-3 się do niego zalicza, czy też nie. Zgodnie z obowiązującym stanem rzeczy, komórki prawdziwie wielokomórkowego organizmu mogą prztrwać tylko jako część bardziej złożonej całości, a nie “kapsuły kolonizacyjne”. Dlatego bardziej trafne byłoby nazywanie HS-3 mianem prokariota z przejściowym stadium wielokomórkowym.